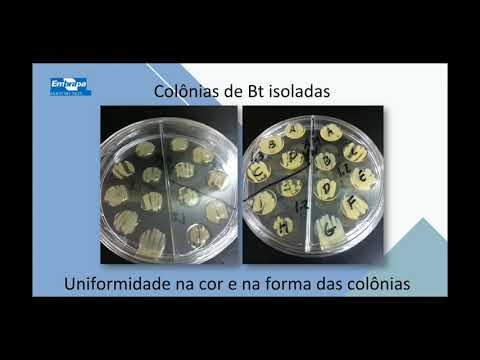

BUSCA AGROSOFT
Busca por data = "Dia: 30 - Mês: 06 - Ano: 2020" (mais recente para a mais antiga)1: AGROTINS 2020 - MANEJO SUSTENTÁVEL DA PALHA DO ARROZ PÓS COLHEITA
 Publicado em 2020-06-30 19:24:42 por #Embrapa [190 hits]
Publicado em 2020-06-30 19:24:42 por #Embrapa [190 hits]
Participação da Embrapa na Agrotins 2020, primeiro grande evento agropecuário nacional totalmente digital. A empresa participou por meio de várias de suas Unidades de Pesquisa....
 Publicado em 2020-06-30 19:24:42 por #Embrapa [190 hits]
Publicado em 2020-06-30 19:24:42 por #Embrapa [190 hits]Participação da Embrapa na Agrotins 2020, primeiro grande evento agropecuário nacional totalmente digital. A empresa participou por meio de várias de suas Unidades de Pesquisa....
2: PROGRAMA MAIS PECUÁRIA - 29/06/20
 Publicado em 2020-06-30 19:24:10 por #CanalDoBoi [202 hits]
Publicado em 2020-06-30 19:24:10 por #CanalDoBoi [202 hits]
Envie sua dúvida ou sugestão de pauta no WhatsApp: (67) 99264-7810....
 Publicado em 2020-06-30 19:24:10 por #CanalDoBoi [202 hits]
Publicado em 2020-06-30 19:24:10 por #CanalDoBoi [202 hits]Envie sua dúvida ou sugestão de pauta no WhatsApp: (67) 99264-7810....
3: AGROTINS 2020 - MANEJO DO CAPIM ELEFANTE PARA PRODUÇÃO DE SILAGEM
 Publicado em 2020-06-30 19:23:56 por #Embrapa [194 hits]
Publicado em 2020-06-30 19:23:56 por #Embrapa [194 hits]
Participação da Embrapa na Agrotins 2020, primeiro grande evento agropecuário nacional totalmente digital. A empresa participou por meio de várias de suas Unidades de Pesquisa....
 Publicado em 2020-06-30 19:23:56 por #Embrapa [194 hits]
Publicado em 2020-06-30 19:23:56 por #Embrapa [194 hits]Participação da Embrapa na Agrotins 2020, primeiro grande evento agropecuário nacional totalmente digital. A empresa participou por meio de várias de suas Unidades de Pesquisa....
4: LIVE - NUTRIÇÃO E GESTÃO DE REBANHO LEITEIRO
 Publicado em 2020-06-30 19:23:13 por #EmaterRS [209 hits]
Publicado em 2020-06-30 19:23:13 por #EmaterRS [209 hits]
Esta LIVE é referente ao assunto "Nutrição e Gestão de Rebanho Leiteiro" e terá compartilhamento simultâneo nas redes sociais da Asbraer, Emater|RS e Emater|PA....
 Publicado em 2020-06-30 19:23:13 por #EmaterRS [209 hits]
Publicado em 2020-06-30 19:23:13 por #EmaterRS [209 hits]Esta LIVE é referente ao assunto "Nutrição e Gestão de Rebanho Leiteiro" e terá compartilhamento simultâneo nas redes sociais da Asbraer, Emater|RS e Emater|PA....
5: LIVE - MERCADO FUTURO DO BOI GORDO E AS OPORTUNIDADES PARA O PRODUTOR RURAL
 Publicado em 2020-06-30 19:22:55 por #Senar [235 hits]
Publicado em 2020-06-30 19:22:55 por #Senar [235 hits]
Antonio Pitangui de Salvo - Presidente da comissão nacional de bovinocultura de corte - CNA Victor Campanelli - Diretor Executivo da Agro Pastoril Paschoal Campanelli João Oliveira Neto Go...
 Publicado em 2020-06-30 19:22:55 por #Senar [235 hits]
Publicado em 2020-06-30 19:22:55 por #Senar [235 hits]Antonio Pitangui de Salvo - Presidente da comissão nacional de bovinocultura de corte - CNA Victor Campanelli - Diretor Executivo da Agro Pastoril Paschoal Campanelli João Oliveira Neto Go...
6: SISTEMAS DE PRODUÇÃO INTENSIVA DE OVINOS DE CORTE
 Publicado em 2020-06-30 19:22:34 por #Embrapa [292 hits]
Publicado em 2020-06-30 19:22:34 por #Embrapa [292 hits]
O analista Anísio Lima Neto e o pesquisador Paulo Fernando Vieira falarão sobre questões relacionadas à ecofisiologia das pastagens e de manejo animal, para permitir maximizar a produção vegetal...
 Publicado em 2020-06-30 19:22:34 por #Embrapa [292 hits]
Publicado em 2020-06-30 19:22:34 por #Embrapa [292 hits]O analista Anísio Lima Neto e o pesquisador Paulo Fernando Vieira falarão sobre questões relacionadas à ecofisiologia das pastagens e de manejo animal, para permitir maximizar a produção vegetal...
7: SUMÁRIO DE TOUROS E MATRIZES GUZERÁ JUNHO/2020 PNMGUL - EMBRAPA/CBMG²
 Publicado em 2020-06-30 19:22:06 por #Embrapa [0 hits]
Publicado em 2020-06-30 19:22:06 por #Embrapa [0 hits]
...
 Publicado em 2020-06-30 19:22:06 por #Embrapa [0 hits]
Publicado em 2020-06-30 19:22:06 por #Embrapa [0 hits]...
8: WEBINAR "SYSTEM APPROACH PARA MAMÃO"
 Publicado em 2020-06-30 19:21:13 por #Embrapa [214 hits]
Publicado em 2020-06-30 19:21:13 por #Embrapa [214 hits]
Palestrante: Antonio Souza do Nascimento (Embrapa Mandioca e Fruticultura) Moderador: Paulo Ernesto Meissner Filho (Embrapa Mandioca e Fruticultura) Data: 30/6/020 às 14h Realização: Embrapa ...
 Publicado em 2020-06-30 19:21:13 por #Embrapa [214 hits]
Publicado em 2020-06-30 19:21:13 por #Embrapa [214 hits]Palestrante: Antonio Souza do Nascimento (Embrapa Mandioca e Fruticultura) Moderador: Paulo Ernesto Meissner Filho (Embrapa Mandioca e Fruticultura) Data: 30/6/020 às 14h Realização: Embrapa ...
9: EXISTE CICLONE BOMBA?
 Publicado em 2020-06-30 19:17:49 por #Climatempo [197 hits]
Publicado em 2020-06-30 19:17:49 por #Climatempo [197 hits]
Saiba mais sobre esta expressão que está circulando nas mídias nesta semana...
 Publicado em 2020-06-30 19:17:49 por #Climatempo [197 hits]
Publicado em 2020-06-30 19:17:49 por #Climatempo [197 hits]Saiba mais sobre esta expressão que está circulando nas mídias nesta semana...
10: PREVISÃO SUL - SITUAÇÃO DE ALERTA
 Publicado em 2020-06-30 19:15:24 por #Climatempo [200 hits]
Publicado em 2020-06-30 19:15:24 por #Climatempo [200 hits]
Boletim de previsão do tempo contendo informações sobre previsão, temperatura mínima e máxima prevista, além de destaques relevantes dos últimos dias....
 Publicado em 2020-06-30 19:15:24 por #Climatempo [200 hits]
Publicado em 2020-06-30 19:15:24 por #Climatempo [200 hits]Boletim de previsão do tempo contendo informações sobre previsão, temperatura mínima e máxima prevista, além de destaques relevantes dos últimos dias....
11: PREVISÃO SUDESTE - NOVA FRENTE FRIA INFLUENCIA A REGIÃO
 Publicado em 2020-06-30 19:14:54 por #Climatempo [208 hits]
Publicado em 2020-06-30 19:14:54 por #Climatempo [208 hits]
Boletim de previsão do tempo contendo informações sobre previsão, temperatura mínima e máxima prevista, além de destaques relevantes dos últimos dias....
 Publicado em 2020-06-30 19:14:54 por #Climatempo [208 hits]
Publicado em 2020-06-30 19:14:54 por #Climatempo [208 hits]Boletim de previsão do tempo contendo informações sobre previsão, temperatura mínima e máxima prevista, além de destaques relevantes dos últimos dias....
12: PREVISÃO CENTRO-OESTE - RAJADAS DE VENTO FORTE EM MS
 Publicado em 2020-06-30 19:14:46 por #Climatempo [192 hits]
Publicado em 2020-06-30 19:14:46 por #Climatempo [192 hits]
Boletim de previsão do tempo contendo informações sobre previsão, temperatura mínima e máxima prevista, além de destaques relevantes dos últimos dias....
 Publicado em 2020-06-30 19:14:46 por #Climatempo [192 hits]
Publicado em 2020-06-30 19:14:46 por #Climatempo [192 hits]Boletim de previsão do tempo contendo informações sobre previsão, temperatura mínima e máxima prevista, além de destaques relevantes dos últimos dias....
13: PREVISÃO NORDESTE - AR SECO PREDOMINA
 Publicado em 2020-06-30 19:14:35 por #Climatempo [190 hits]
Publicado em 2020-06-30 19:14:35 por #Climatempo [190 hits]
Boletim de previsão do tempo contendo informações sobre previsão, temperatura mínima e máxima prevista, além de destaques relevantes dos últimos dias....
 Publicado em 2020-06-30 19:14:35 por #Climatempo [190 hits]
Publicado em 2020-06-30 19:14:35 por #Climatempo [190 hits]Boletim de previsão do tempo contendo informações sobre previsão, temperatura mínima e máxima prevista, além de destaques relevantes dos últimos dias....
14: PREVISÃO NORTE - CHUVA FORTE NA REGIÃO
 Publicado em 2020-06-30 19:14:13 por #Climatempo [195 hits]
Publicado em 2020-06-30 19:14:13 por #Climatempo [195 hits]
Boletim de previsão do tempo contendo informações sobre previsão, temperatura mínima e máxima prevista, além de destaques relevantes dos últimos dias....
 Publicado em 2020-06-30 19:14:13 por #Climatempo [195 hits]
Publicado em 2020-06-30 19:14:13 por #Climatempo [195 hits]Boletim de previsão do tempo contendo informações sobre previsão, temperatura mínima e máxima prevista, além de destaques relevantes dos últimos dias....
15: EXPORTAÇÃO DE GADO VIVO PARA TURQUIA CAI 68%
 Publicado em 2020-06-30 19:13:54 por #CanalRural [210 hits]
Publicado em 2020-06-30 19:13:54 por #CanalRural [210 hits]
As exportações de gado vivo registraram uma desaceleração nos últimos cinco meses, com a Turquia fora das compras. O país é, historicamente, o principal comprador dos animais brasileiros, mas r...
 Publicado em 2020-06-30 19:13:54 por #CanalRural [210 hits]
Publicado em 2020-06-30 19:13:54 por #CanalRural [210 hits]As exportações de gado vivo registraram uma desaceleração nos últimos cinco meses, com a Turquia fora das compras. O país é, historicamente, o principal comprador dos animais brasileiros, mas r...
16: PROGRAMA AGRICULTURA BR - 30/06/20
 Publicado em 2020-06-30 19:12:32 por #CanalDoBoi [187 hits]
Publicado em 2020-06-30 19:12:32 por #CanalDoBoi [187 hits]
Envie sua dúvida ou sugestão de pauta no WhatsApp: (67) 99264-7810...
 Publicado em 2020-06-30 19:12:32 por #CanalDoBoi [187 hits]
Publicado em 2020-06-30 19:12:32 por #CanalDoBoi [187 hits]Envie sua dúvida ou sugestão de pauta no WhatsApp: (67) 99264-7810...
17: LIVE: O USO DA BIOTECNOLOGIA NA AGRICULTURA
 Publicado em 2020-06-30 19:09:57 por #Faeg [240 hits]
Publicado em 2020-06-30 19:09:57 por #Faeg [240 hits]
...
 Publicado em 2020-06-30 19:09:57 por #Faeg [240 hits]
Publicado em 2020-06-30 19:09:57 por #Faeg [240 hits]...
18: PREMIAÇÃO CAMPANHA NACIONAL DE COMBATE À EROSÃO
 Publicado em 2020-06-30 19:09:24 por #Embrapa [206 hits]
Publicado em 2020-06-30 19:09:24 por #Embrapa [206 hits]
O desafio foi lançado em 5 de dezembro de 2019 (Dia Mundial do Solo), pela Embrapa Solos, em parceria com o Ministério da Agricultura, Pecuária e Abastecimento , Sociedade Brasileira de Ciência do...
 Publicado em 2020-06-30 19:09:24 por #Embrapa [206 hits]
Publicado em 2020-06-30 19:09:24 por #Embrapa [206 hits]O desafio foi lançado em 5 de dezembro de 2019 (Dia Mundial do Solo), pela Embrapa Solos, em parceria com o Ministério da Agricultura, Pecuária e Abastecimento , Sociedade Brasileira de Ciência do...
19: BRS IMPERIAL VARIEDADE DE ABACAXI COM RESISTÊNCIA A FUSARIOSE
 Publicado em 2020-06-30 19:07:25 por #Embrapa [204 hits]
Publicado em 2020-06-30 19:07:25 por #Embrapa [204 hits]
Participação da Embrapa na Agrotins 2020, primeiro grande evento agropecuário nacional totalmente digital. A empresa participou por meio de várias de suas Unidades de Pesquisa....
 Publicado em 2020-06-30 19:07:25 por #Embrapa [204 hits]
Publicado em 2020-06-30 19:07:25 por #Embrapa [204 hits]Participação da Embrapa na Agrotins 2020, primeiro grande evento agropecuário nacional totalmente digital. A empresa participou por meio de várias de suas Unidades de Pesquisa....
20: AGROTINS 2020 - PALESTRA CONTROLE BIOLÓGICO DE INSETOS
 Publicado em 2020-06-30 19:06:35 por #Embrapa [207 hits]
Publicado em 2020-06-30 19:06:35 por #Embrapa [207 hits]
Participação da Embrapa na Agrotins 2020, primeiro grande evento agropecuário nacional totalmente digital. A empresa participou por meio de várias de suas Unidades de Pesquisa....
 Publicado em 2020-06-30 19:06:35 por #Embrapa [207 hits]
Publicado em 2020-06-30 19:06:35 por #Embrapa [207 hits]Participação da Embrapa na Agrotins 2020, primeiro grande evento agropecuário nacional totalmente digital. A empresa participou por meio de várias de suas Unidades de Pesquisa....
21: AGROTINS 2020 - PALESTRA CONTROLE BIOLÓGICO DE PRAGAS
 Publicado em 2020-06-30 19:06:11 por #Embrapa [195 hits]
Publicado em 2020-06-30 19:06:11 por #Embrapa [195 hits]
Participação da Embrapa na Agrotins 2020, primeiro grande evento agropecuário nacional totalmente digital. A empresa participou por meio de várias de suas Unidades de Pesquisa....
 Publicado em 2020-06-30 19:06:11 por #Embrapa [195 hits]
Publicado em 2020-06-30 19:06:11 por #Embrapa [195 hits]Participação da Embrapa na Agrotins 2020, primeiro grande evento agropecuário nacional totalmente digital. A empresa participou por meio de várias de suas Unidades de Pesquisa....
22: AGROTINS 2020 - PALESTRA CONSÓRCIO DE AÇAÍ COM BANANA
 Publicado em 2020-06-30 19:05:59 por #Embrapa [210 hits]
Publicado em 2020-06-30 19:05:59 por #Embrapa [210 hits]
Participação da Embrapa na Agrotins 2020, primeiro grande evento agropecuário nacional totalmente digital. A empresa participou por meio de várias de suas Unidades de Pesquisa....
 Publicado em 2020-06-30 19:05:59 por #Embrapa [210 hits]
Publicado em 2020-06-30 19:05:59 por #Embrapa [210 hits]Participação da Embrapa na Agrotins 2020, primeiro grande evento agropecuário nacional totalmente digital. A empresa participou por meio de várias de suas Unidades de Pesquisa....
23: AGROTINS 2020 - PALESTRA ASPECTOS PARA ESCOLHA DA FORRAGEIRA
 Publicado em 2020-06-30 19:05:42 por #Embrapa [208 hits]
Publicado em 2020-06-30 19:05:42 por #Embrapa [208 hits]
Participação da Embrapa na Agrotins 2020, primeiro grande evento agropecuário nacional totalmente digital. A empresa participou por meio de várias de suas Unidades de Pesquisa....
 Publicado em 2020-06-30 19:05:42 por #Embrapa [208 hits]
Publicado em 2020-06-30 19:05:42 por #Embrapa [208 hits]Participação da Embrapa na Agrotins 2020, primeiro grande evento agropecuário nacional totalmente digital. A empresa participou por meio de várias de suas Unidades de Pesquisa....
24: WEBINAR 2020 - CANA-DE-AÇÚCAR RESISTENTE A INSETOS-PRAGA E HERBICIDA
 Publicado em 2020-06-30 19:05:07 por #Embrapa [187 hits]
Publicado em 2020-06-30 19:05:07 por #Embrapa [187 hits]
Assista o Webinar da Embrapa Agroenergia - Tema: Cana-de-açúcar resistente a insetos-praga e herbicida com o pesquisador Hugo Molinari....
 Publicado em 2020-06-30 19:05:07 por #Embrapa [187 hits]
Publicado em 2020-06-30 19:05:07 por #Embrapa [187 hits]Assista o Webinar da Embrapa Agroenergia - Tema: Cana-de-açúcar resistente a insetos-praga e herbicida com o pesquisador Hugo Molinari....
25: AGROTINS 2020 - OS MILHARES DE TIPOS DE ARROZ
 Publicado em 2020-06-30 19:04:52 por #Embrapa [188 hits]
Publicado em 2020-06-30 19:04:52 por #Embrapa [188 hits]
Participação da Embrapa na Agrotins 2020, primeiro grande evento agropecuário nacional totalmente digital. A empresa participou por meio de várias de suas Unidades de Pesquisa....
 Publicado em 2020-06-30 19:04:52 por #Embrapa [188 hits]
Publicado em 2020-06-30 19:04:52 por #Embrapa [188 hits]Participação da Embrapa na Agrotins 2020, primeiro grande evento agropecuário nacional totalmente digital. A empresa participou por meio de várias de suas Unidades de Pesquisa....
26: PROGRAMA BOM DIA PRODUTOR - 30/06/20
 Publicado em 2020-06-30 19:04:24 por #CanalDoBoi [197 hits]
Publicado em 2020-06-30 19:04:24 por #CanalDoBoi [197 hits]
Envie sua dúvida ou sugestão de pauta no WhatsApp: (67) 99264-7810....
 Publicado em 2020-06-30 19:04:24 por #CanalDoBoi [197 hits]
Publicado em 2020-06-30 19:04:24 por #CanalDoBoi [197 hits]Envie sua dúvida ou sugestão de pauta no WhatsApp: (67) 99264-7810....
27: LOS ANGELES BATE OS 100 MIL CASOS E CALIFÓRNIA REAVALIA REABERTURA
 Publicado em 2020-06-30 14:06:31 por #EFE [204 hits]
Publicado em 2020-06-30 14:06:31 por #EFE [204 hits]
O condado de Los Angeles passou dos 100 mil casos de coronavírus depois de contabilizar 2.903 novos positivos na segunda-feira, recorde para um único dia, assim como outras cidades da Califórnia, o...
 Publicado em 2020-06-30 14:06:31 por #EFE [204 hits]
Publicado em 2020-06-30 14:06:31 por #EFE [204 hits]O condado de Los Angeles passou dos 100 mil casos de coronavírus depois de contabilizar 2.903 novos positivos na segunda-feira, recorde para um único dia, assim como outras cidades da Califórnia, o...
28: PRODUTORES SOFREM COM FALTA DE SORO CONTRA PICADA DE COBRA
 Publicado em 2020-06-30 13:52:26 por #CanalRural [227 hits]
Publicado em 2020-06-30 13:52:26 por #CanalRural [227 hits]
A escassez de soro antiofídico nos hospitais e clínicas médicas do interior de Mato Grosso preocupa produtores e a população da zona rural. As doses concentradas nas cidades-polo e transportadas ...
 Publicado em 2020-06-30 13:52:26 por #CanalRural [227 hits]
Publicado em 2020-06-30 13:52:26 por #CanalRural [227 hits]A escassez de soro antiofídico nos hospitais e clínicas médicas do interior de Mato Grosso preocupa produtores e a população da zona rural. As doses concentradas nas cidades-polo e transportadas ...
29: ALGODÃO ORGÂNICO EM CONSÓRCIOS AGROALIMENTARES NO SEMIÁRIDO
 Publicado em 2020-06-30 10:53:11 por #Embrapa [222 hits]
Publicado em 2020-06-30 10:53:11 por #Embrapa [222 hits]
A Embrapa realiza nesta terça-feira, 30/06/20, a partir das 9 horas uma live com o tema "Algodão orgânico em consórcios agroalimentares no Semiárido". O objetivo é apresentar os avanços obtidos...
 Publicado em 2020-06-30 10:53:11 por #Embrapa [222 hits]
Publicado em 2020-06-30 10:53:11 por #Embrapa [222 hits]A Embrapa realiza nesta terça-feira, 30/06/20, a partir das 9 horas uma live com o tema "Algodão orgânico em consórcios agroalimentares no Semiárido". O objetivo é apresentar os avanços obtidos...
30: AGROTINS 2020 - IRRIGAÇÃO DE PASTAGENS TOMADA DE DECISÃO
 Publicado em 2020-06-30 10:52:45 por #Embrapa [208 hits]
Publicado em 2020-06-30 10:52:45 por #Embrapa [208 hits]
Participação da Embrapa na Agrotins 2020, primeiro grande evento agropecuário nacional totalmente digital. A empresa participou por meio de várias de suas Unidades de Pesquisa....
 Publicado em 2020-06-30 10:52:45 por #Embrapa [208 hits]
Publicado em 2020-06-30 10:52:45 por #Embrapa [208 hits]Participação da Embrapa na Agrotins 2020, primeiro grande evento agropecuário nacional totalmente digital. A empresa participou por meio de várias de suas Unidades de Pesquisa....
31: PROGRAMA FALA CARLÃO - 29/06/20
 Publicado em 2020-06-30 10:51:58 por #CanalDoBoi [190 hits]
Publicado em 2020-06-30 10:51:58 por #CanalDoBoi [190 hits]
Envie sua dúvida ou sugestão de pauta no WhatsApp: (67) 99264-7810....
 Publicado em 2020-06-30 10:51:58 por #CanalDoBoi [190 hits]
Publicado em 2020-06-30 10:51:58 por #CanalDoBoi [190 hits]Envie sua dúvida ou sugestão de pauta no WhatsApp: (67) 99264-7810....
32: AGROTINS 2020 - LANÇAMENTO DA GEO MATOPIBA
 Publicado em 2020-06-30 10:51:35 por #Embrapa [213 hits]
Publicado em 2020-06-30 10:51:35 por #Embrapa [213 hits]
Participação da Embrapa na Agrotins 2020, primeiro grande evento agropecuário nacional totalmente digital. A empresa participou por meio de várias de suas Unidades de Pesquisa....
 Publicado em 2020-06-30 10:51:35 por #Embrapa [213 hits]
Publicado em 2020-06-30 10:51:35 por #Embrapa [213 hits]Participação da Embrapa na Agrotins 2020, primeiro grande evento agropecuário nacional totalmente digital. A empresa participou por meio de várias de suas Unidades de Pesquisa....
33: RECEITAS COM MORANGO - MOUSSE, VITAMINA E CUCA
 Publicado em 2020-06-30 10:51:25 por #EmaterRS [248 hits]
Publicado em 2020-06-30 10:51:25 por #EmaterRS [248 hits]
Mousse, vitamina e cuca de morango. Extensionistas da Emater/RS ensinam a aproveitar essa fruta deliciosa com receitas práticas....
 Publicado em 2020-06-30 10:51:25 por #EmaterRS [248 hits]
Publicado em 2020-06-30 10:51:25 por #EmaterRS [248 hits]Mousse, vitamina e cuca de morango. Extensionistas da Emater/RS ensinam a aproveitar essa fruta deliciosa com receitas práticas....
34: PROGRAMA TERRA PECUÁRIA - 29/06/20
 Publicado em 2020-06-30 10:51:13 por #CanalDoBoi [211 hits]
Publicado em 2020-06-30 10:51:13 por #CanalDoBoi [211 hits]
Envie sua dúvida ou sugestão de pauta no WhatsApp: (67) 99264-7810 ...
 Publicado em 2020-06-30 10:51:13 por #CanalDoBoi [211 hits]
Publicado em 2020-06-30 10:51:13 por #CanalDoBoi [211 hits]Envie sua dúvida ou sugestão de pauta no WhatsApp: (67) 99264-7810 ...
35: EMPRESÁRIA FALA DA OBTENÇÃO DE FINANCIAMENTO EM TROCA DE PRODUTO
 Publicado em 2020-06-30 10:43:54 por #CanalDoBoi [193 hits]
Publicado em 2020-06-30 10:43:54 por #CanalDoBoi [193 hits]
Envie sua dúvida ou sugestão de pauta no WhatsApp: (67) 99264-7810....
 Publicado em 2020-06-30 10:43:54 por #CanalDoBoi [193 hits]
Publicado em 2020-06-30 10:43:54 por #CanalDoBoi [193 hits]Envie sua dúvida ou sugestão de pauta no WhatsApp: (67) 99264-7810....
36: VEJA ONDE COVID-19 AVANÇA E RECUA NO BRASIL
 Publicado em 2020-06-30 07:42:53 por #BBC [210 hits]
Publicado em 2020-06-30 07:42:53 por #BBC [210 hits]
Neste vídeo, o repórter Matheus Magenta mostra como os Estados do país estão em diferentes momentos na pandemia: enquanto alguns veem os casos caindo, outros têm no máximo uma estabilização. M...
 Publicado em 2020-06-30 07:42:53 por #BBC [210 hits]
Publicado em 2020-06-30 07:42:53 por #BBC [210 hits]Neste vídeo, o repórter Matheus Magenta mostra como os Estados do país estão em diferentes momentos na pandemia: enquanto alguns veem os casos caindo, outros têm no máximo uma estabilização. M...
37: UFG PREVÊ COLAPSO DO SISTEMA DE SAÚDE DO ESTADO DE GOIÁS
 Publicado em 2020-06-30 07:42:37 por #TVBrasil [301 hits]
Publicado em 2020-06-30 07:42:37 por #TVBrasil [301 hits]
O governo de Goiás publicou hoje um decreto que prevê o fechamento alternado do comércio por 14 dias. O objetivo é tentar evitar o colapso do sistema hospitalar já no mês que vem, como mostra um...
 Publicado em 2020-06-30 07:42:37 por #TVBrasil [301 hits]
Publicado em 2020-06-30 07:42:37 por #TVBrasil [301 hits]O governo de Goiás publicou hoje um decreto que prevê o fechamento alternado do comércio por 14 dias. O objetivo é tentar evitar o colapso do sistema hospitalar já no mês que vem, como mostra um...
38: FIOCRUZ VAI PRODUZIR VACINA CONTRA COVID-19 CRIADA EM OXFORD
 Publicado em 2020-06-30 07:42:05 por #TVBrasil [230 hits]
Publicado em 2020-06-30 07:42:05 por #TVBrasil [230 hits]
A Fundação Osvaldo Cruz vai produzir a vacina que está sendo desenvolvida pela Universidade de Oxford. Já a Universidade Federal de São Paulo, a Unifesp, apoia os testes no Brasil. Os especialist...
 Publicado em 2020-06-30 07:42:05 por #TVBrasil [230 hits]
Publicado em 2020-06-30 07:42:05 por #TVBrasil [230 hits]A Fundação Osvaldo Cruz vai produzir a vacina que está sendo desenvolvida pela Universidade de Oxford. Já a Universidade Federal de São Paulo, a Unifesp, apoia os testes no Brasil. Os especialist...
39: REMÉDIO PARA HEPATITE C PODE IMPEDIR REPRODUÇÃO DO CORONAVÍRUS
 Publicado em 2020-06-30 07:41:52 por #Band [203 hits]
Publicado em 2020-06-30 07:41:52 por #Band [203 hits]
No Rio de Janeiro, uma pesquisa da Fiocruz identificou que um remédio para hepatite C pode ser eficaz no combate à covid-19....
 Publicado em 2020-06-30 07:41:52 por #Band [203 hits]
Publicado em 2020-06-30 07:41:52 por #Band [203 hits]No Rio de Janeiro, uma pesquisa da Fiocruz identificou que um remédio para hepatite C pode ser eficaz no combate à covid-19....
40: UNIÃO EUROPEIA COMEÇA A ABRIR FRONTEIRAS; ENTRADA DE BRASILEIROS ESTÁ PROÍBIDA
 Publicado em 2020-06-30 07:41:41 por #Band [196 hits]
Publicado em 2020-06-30 07:41:41 por #Band [196 hits]
Depois de três meses, a União Europeia vai reabrir as fronteiras para cidadãos de 15 países onde o coronavírus já está sob controle. Brasil e Estados Unidos ficaram fora da lista....
 Publicado em 2020-06-30 07:41:41 por #Band [196 hits]
Publicado em 2020-06-30 07:41:41 por #Band [196 hits]Depois de três meses, a União Europeia vai reabrir as fronteiras para cidadãos de 15 países onde o coronavírus já está sob controle. Brasil e Estados Unidos ficaram fora da lista....
41: A TEMIDA CASCAVEL! - RICHARD RASMUSSEN
 Publicado em 2020-06-30 07:41:20 por #RichardRasmussen [208 hits]
Publicado em 2020-06-30 07:41:20 por #RichardRasmussen [208 hits]
Olá, eu sou Richard Rasmussen e fiqueemcasa e assista mais um Que bicho é esse comigo Dessa vez vamos falar sobre a temida Cascavel. Espero que gostem!...
 Publicado em 2020-06-30 07:41:20 por #RichardRasmussen [208 hits]
Publicado em 2020-06-30 07:41:20 por #RichardRasmussen [208 hits]Olá, eu sou Richard Rasmussen e fiqueemcasa e assista mais um Que bicho é esse comigo Dessa vez vamos falar sobre a temida Cascavel. Espero que gostem!...
42: A CIDADE TURÍSTICA QUE FOI TOMADA POR MACACOS NA QUARENTENA DOS HUMANOS
 Publicado em 2020-06-30 07:41:10 por #BBC [217 hits]
Publicado em 2020-06-30 07:41:10 por #BBC [217 hits]
A pandemia do coronavírus transformou a forma como vivemos. Mas em uma cidade na Tailândia, os efeitos foram particularmente sentidos pelos moradores. Em Lopburi, os macacos, outrora uma atração t...
 Publicado em 2020-06-30 07:41:10 por #BBC [217 hits]
Publicado em 2020-06-30 07:41:10 por #BBC [217 hits]A pandemia do coronavírus transformou a forma como vivemos. Mas em uma cidade na Tailândia, os efeitos foram particularmente sentidos pelos moradores. Em Lopburi, os macacos, outrora uma atração t...
43: CULTIVO DE MAMÃO COM FOCO EM EXPORTAÇÃO É TEMA DE WEBINAR
Publicado em 30/06/2020 às 06:43: por #Embrapa [201 hits]
Nesta terça-feira, dia 30 de junho de 2020, às 14 horas, a Embrapa Mandioca e Fruticultura (Cruz das Almas/BA), Unidade da Empresa Brasileira de Pesquisa Agropecuária (Embrapa), vinculada ao Mi...
Publicado em 30/06/2020 às 06:43: por #Embrapa [201 hits]
Nesta terça-feira, dia 30 de junho de 2020, às 14 horas, a Embrapa Mandioca e Fruticultura (Cruz das Almas/BA), Unidade da Empresa Brasileira de Pesquisa Agropecuária (Embrapa), vinculada ao Mi...
44: SUPORTE AGILIZA ALEITAMENTO ARTIFICIAL DE CORDEIROS
Publicado em 30/06/2020 às 06:43: por #Embrapa [210 hits]
Suporte facilita amamentação artificial dos ovinos.Foto: Isabella Barbosa dos Santos Uma ideia simples e barata pode ajudar os produtores de ovinos na hora do aleitamento artificial de cordeiro...
Publicado em 30/06/2020 às 06:43: por #Embrapa [210 hits]
Suporte facilita amamentação artificial dos ovinos.Foto: Isabella Barbosa dos Santos Uma ideia simples e barata pode ajudar os produtores de ovinos na hora do aleitamento artificial de cordeiro...
45: AUMENTO DE PRODUTIVIDADE DE ATÉ 50% COM NOVAS VARIEDADES DE MANDIOCA DA EMBRAPA
Publicado em 30/06/2020 às 06:42: por #Embrapa [223 hits]
Foto: Auro Akio Otsubo As variedades de mandioca da Embrapa para a indústria BRS CS01, BRS 420 e as de mesa: BRS 396, BRS 399 e BRS 429 são resultado de trabalho em conjunto de várias Unidades...
Publicado em 30/06/2020 às 06:42: por #Embrapa [223 hits]
Foto: Auro Akio Otsubo As variedades de mandioca da Embrapa para a indústria BRS CS01, BRS 420 e as de mesa: BRS 396, BRS 399 e BRS 429 são resultado de trabalho em conjunto de várias Unidades...
46: CUSTOS DE PRODUÇÃO DE SUÍNOS E DE FRANGOS DE CORTE SOBEM EM MAIO DE 2020
Publicado em 30/06/2020 às 06:39: por #Embrapa [205 hits]
Os custos de produção de suínos e de frangos de corte calculados pela CIAS, a Central de Inteligência de Aves e Suínos da Embrapa, voltaram a ter mais um mês de alta em maio, subindo 1% e 0,...
Publicado em 30/06/2020 às 06:39: por #Embrapa [205 hits]
Os custos de produção de suínos e de frangos de corte calculados pela CIAS, a Central de Inteligência de Aves e Suínos da Embrapa, voltaram a ter mais um mês de alta em maio, subindo 1% e 0,...
47: O PROTAGONISMO DO BRASIL NA PRODUÇÃO MUNDIAL DE PESCADO
Publicado em 30/06/2020 às 06:33: por #Embrapa [299 hits]
• O Brasil ocupa apenas a 13ª posição na produção de peixes em cativeiro, e é o 8º na produção de peixes de água doce. • O monitoramento dos estoques pesqueiros indica que as espéc...
Publicado em 30/06/2020 às 06:33: por #Embrapa [299 hits]
• O Brasil ocupa apenas a 13ª posição na produção de peixes em cativeiro, e é o 8º na produção de peixes de água doce. • O monitoramento dos estoques pesqueiros indica que as espéc...
48: BRS PRINCESA: VARIEDADE DE BANANA MAÇÃ, COM RESISTÊNCIA A MURCHA DE FUSARIUM
 Publicado em 2020-06-30 06:30:59 por #Embrapa [188 hits]
Publicado em 2020-06-30 06:30:59 por #Embrapa [188 hits]
Participação da Embrapa na Agrotins 2020, primeiro grande evento agropecuário nacional totalmente digital. A empresa participou por meio de várias de suas Unidades de Pesquisa....
 Publicado em 2020-06-30 06:30:59 por #Embrapa [188 hits]
Publicado em 2020-06-30 06:30:59 por #Embrapa [188 hits]Participação da Embrapa na Agrotins 2020, primeiro grande evento agropecuário nacional totalmente digital. A empresa participou por meio de várias de suas Unidades de Pesquisa....
49: RECURSOS DO PRONAF CRESCEM R$ 25 BILHÕES EM 20 ANOS
 Publicado em 2020-06-30 06:30:06 por #CanalRural [204 hits]
Publicado em 2020-06-30 06:30:06 por #CanalRural [204 hits]
O crédito rural destinado ao Programa Nacional de Fortalecimento da Agricultura Familiar (Pronaf) cresceu R$ 25 bilhões em 20 anos. De acordo com o comentarista do Canal Rural e ex-secretário d...
 Publicado em 2020-06-30 06:30:06 por #CanalRural [204 hits]
Publicado em 2020-06-30 06:30:06 por #CanalRural [204 hits]O crédito rural destinado ao Programa Nacional de Fortalecimento da Agricultura Familiar (Pronaf) cresceu R$ 25 bilhões em 20 anos. De acordo com o comentarista do Canal Rural e ex-secretário d...
50: MINISTÉRIO DA ECONOMIA REALIZA AJUSTES NO PROGRAMA DE GARANTIA DA ATIVIDADE AGRO
Publicado em 30/06/2020 às 06:29: por #Sebrae [192 hits]
A mudança no Manual de Crédito Rural passa a vigora a partir do próximo dia primeiro de julho O Ministério da Economia publicou no Diário Oficial da União uma resolução que ajusta as alíqu...
Publicado em 30/06/2020 às 06:29: por #Sebrae [192 hits]
A mudança no Manual de Crédito Rural passa a vigora a partir do próximo dia primeiro de julho O Ministério da Economia publicou no Diário Oficial da União uma resolução que ajusta as alíqu...
51: PRINCIPAL DESAFIO DA CONVIVÊNCIA COM A SECA É AUMENTAR DISPONIBILIDADE DE ÁGUA
Publicado em 30/06/2020 às 06:27: por #Embrapa [205 hits]
Caatinga. Foto: Fernanda Birolo. A equipe do Portfólio Convivência com a Seca no Semiárido, que discute as relevâncias, as tecnologias e as prioridades do setor de produtos, mostra um documen...
Publicado em 30/06/2020 às 06:27: por #Embrapa [205 hits]
Caatinga. Foto: Fernanda Birolo. A equipe do Portfólio Convivência com a Seca no Semiárido, que discute as relevâncias, as tecnologias e as prioridades do setor de produtos, mostra um documen...
52: PROTEÍNAS E ALIMENTOS À BASE DE VEGETAIS SERÃO TEMAS DE LIVE DA EMBRAPA
Publicado em 30/06/2020 às 06:23: por #Embrapa [200 hits]
Os principais representantes dos pulses como fontes de proteínas vegetais são grão de bico, ervilha, feijão e lentilha. Foto: Henrique Carvalho/Embrapa Hortaliças O desenvolvimento de prote�...
Publicado em 30/06/2020 às 06:23: por #Embrapa [200 hits]
Os principais representantes dos pulses como fontes de proteínas vegetais são grão de bico, ervilha, feijão e lentilha. Foto: Henrique Carvalho/Embrapa Hortaliças O desenvolvimento de prote�...
53: MANEJO DE DOENÇAS NA CULTURA DO TRIGO
Publicado em 30/06/2020 às 06:16: por #DestaqueRural [235 hits]
Vamos conversar com o professor Dr. Erlei Melo Reis, sobre o atual cenário da cultura do Trigo....
Publicado em 30/06/2020 às 06:16: por #DestaqueRural [235 hits]
Vamos conversar com o professor Dr. Erlei Melo Reis, sobre o atual cenário da cultura do Trigo....
54: CONSTRUINDO A SUSTENTABILIDADE DO ARROZ IRRIGADO NO TOCONTINS
 Publicado em 2020-06-30 06:15:57 por #Embrapa [202 hits]
Publicado em 2020-06-30 06:15:57 por #Embrapa [202 hits]
Participação da Embrapa na Agrotins 2020, primeiro grande evento agropecuário nacional totalmente digital. A empresa participou por meio de várias de suas Unidades de Pesquisa....
 Publicado em 2020-06-30 06:15:57 por #Embrapa [202 hits]
Publicado em 2020-06-30 06:15:57 por #Embrapa [202 hits]Participação da Embrapa na Agrotins 2020, primeiro grande evento agropecuário nacional totalmente digital. A empresa participou por meio de várias de suas Unidades de Pesquisa....
55: CAMPANHA AGRO PELA ÁGUA É O DESTAQUE NA EDIÇÃO 1515 DO BOLETIM DA FAEP
 Publicado em 2020-06-30 06:15:45 por #Faep [244 hits]
Publicado em 2020-06-30 06:15:45 por #Faep [244 hits]
A campanha “Agro pela Água” é o destaque na edição 1515 do Boletim Informativo. Confira as ações e o concurso desenvolvidos pelo Sistema FAEP/SENAR-PR que vão promover o uso racional da ág...
 Publicado em 2020-06-30 06:15:45 por #Faep [244 hits]
Publicado em 2020-06-30 06:15:45 por #Faep [244 hits]A campanha “Agro pela Água” é o destaque na edição 1515 do Boletim Informativo. Confira as ações e o concurso desenvolvidos pelo Sistema FAEP/SENAR-PR que vão promover o uso racional da ág...
56: AGROTINS 2020 - ENFEZAMENTOS DO MILHO ETIOLOGIA, SINTOMAS E MANEJO
 Publicado em 2020-06-30 06:15:23 por #Embrapa [207 hits]
Publicado em 2020-06-30 06:15:23 por #Embrapa [207 hits]
Participação da Embrapa na Agrotins 2020, primeiro grande evento agropecuário nacional totalmente digital. A empresa participou por meio de várias de suas Unidades de Pesquisa....
 Publicado em 2020-06-30 06:15:23 por #Embrapa [207 hits]
Publicado em 2020-06-30 06:15:23 por #Embrapa [207 hits]Participação da Embrapa na Agrotins 2020, primeiro grande evento agropecuário nacional totalmente digital. A empresa participou por meio de várias de suas Unidades de Pesquisa....
57: LIVE: HOLDING RURAL - AS VANTAGENS DO PLANEJAMENTO SUCESSÓRIO E TRIBUTÁRIO
 Publicado em 2020-06-30 06:15:04 por #Faeg [218 hits]
Publicado em 2020-06-30 06:15:04 por #Faeg [218 hits]
LIVE: Holding Rural - As vantagens do Planejamento Sucessório e Tributário Acesso nossa página no instragram: https://www.instagram.com/sistemafaeg/...
 Publicado em 2020-06-30 06:15:04 por #Faeg [218 hits]
Publicado em 2020-06-30 06:15:04 por #Faeg [218 hits]LIVE: Holding Rural - As vantagens do Planejamento Sucessório e Tributário Acesso nossa página no instragram: https://www.instagram.com/sistemafaeg/...
58: GOVERNO AMPLIA ACESSO AO CRÉDITO PARA PEQUENOS E MÉDIOS PRODUTORES
 Publicado em 2020-06-30 06:14:38 por #CanalRural [184 hits]
Publicado em 2020-06-30 06:14:38 por #CanalRural [184 hits]
O Conselho Monetário Nacional (CMN) ainda mudou as alíquotas do Proagro para a próxima safra; confira detalhes com a repórter Paola Cuenca, de Brasília. ...
 Publicado em 2020-06-30 06:14:38 por #CanalRural [184 hits]
Publicado em 2020-06-30 06:14:38 por #CanalRural [184 hits]O Conselho Monetário Nacional (CMN) ainda mudou as alíquotas do Proagro para a próxima safra; confira detalhes com a repórter Paola Cuenca, de Brasília. ...
59: MERCADO & COMPANHIA - 29/06/20
 Publicado em 2020-06-30 06:14:15 por #CanalRural [203 hits]
Publicado em 2020-06-30 06:14:15 por #CanalRural [203 hits]
No Mercado&Companhia desta segunda-feira, 29/06/20, acompanhe: Serra Catarinense registra frio intenso e termômetros marcam -0,3 graus no sul do país. Mercado agrícola começa semana monitorando ri...
 Publicado em 2020-06-30 06:14:15 por #CanalRural [203 hits]
Publicado em 2020-06-30 06:14:15 por #CanalRural [203 hits]No Mercado&Companhia desta segunda-feira, 29/06/20, acompanhe: Serra Catarinense registra frio intenso e termômetros marcam -0,3 graus no sul do país. Mercado agrícola começa semana monitorando ri...
60: AGROTINS 2020 - CONTROLE BIOLÓGICO APLICADO À CULTURA DO MILHO
 Publicado em 2020-06-30 06:13:30 por #Embrapa [240 hits]
Publicado em 2020-06-30 06:13:30 por #Embrapa [240 hits]
Participação da Embrapa na Agrotins 2020, primeiro grande evento agropecuário nacional totalmente digital. A empresa participou por meio de várias de suas Unidades de Pesquisa....
Publicado em 2020-06-30 06:13:30 por #Embrapa [240 hits]
Publicado em 2020-06-30 06:13:30 por #Embrapa [240 hits]Participação da Embrapa na Agrotins 2020, primeiro grande evento agropecuário nacional totalmente digital. A empresa participou por meio de várias de suas Unidades de Pesquisa....
61: COMO ESCOLHER ADEQUADAMENTE O COMPONENTE ARBÓREO PARA USO EM LPF
 Publicado em 2020-06-30 06:13:17 por #Embrapa [212 hits]
Publicado em 2020-06-30 06:13:17 por #Embrapa [212 hits]
Participação da Embrapa na Agrotins 2020, primeiro grande evento agropecuário nacional totalmente digital. A empresa participou por meio de várias de suas Unidades de Pesquisa....
 Publicado em 2020-06-30 06:13:17 por #Embrapa [212 hits]
Publicado em 2020-06-30 06:13:17 por #Embrapa [212 hits]Participação da Embrapa na Agrotins 2020, primeiro grande evento agropecuário nacional totalmente digital. A empresa participou por meio de várias de suas Unidades de Pesquisa....
62: ALIMENTOS & TERRITÓRIOS
 Publicado em 2020-06-30 06:09:47 por #Embrapa [216 hits]
Publicado em 2020-06-30 06:09:47 por #Embrapa [216 hits]
Em comemoração ao segundo ano de criação do CENTRO NACIONAL DE PESQUISA EM ALIMENTOS E TERRITÓRIOS, instalado na capital alagoana, a live vai abordar um dos temas inaugurais do trabalho já inici...
 Publicado em 2020-06-30 06:09:47 por #Embrapa [216 hits]
Publicado em 2020-06-30 06:09:47 por #Embrapa [216 hits]Em comemoração ao segundo ano de criação do CENTRO NACIONAL DE PESQUISA EM ALIMENTOS E TERRITÓRIOS, instalado na capital alagoana, a live vai abordar um dos temas inaugurais do trabalho já inici...
63: LIVE: MUSEU DO ZEBU - ATUANDO FORTE
 Publicado em 2020-06-30 06:08:23 por #ABCZ [292 hits]
Publicado em 2020-06-30 06:08:23 por #ABCZ [292 hits]
Bate papo sobre Museu do Zebu, ações educacionais e o desenvolvimento da Turma do Zebuzinho com o Gerente do Museu do Zebu, Thiago Riccioppo, Editor da Bela Vista Cultural, Fábio Ávila e Sócio-di...
 Publicado em 2020-06-30 06:08:23 por #ABCZ [292 hits]
Publicado em 2020-06-30 06:08:23 por #ABCZ [292 hits]Bate papo sobre Museu do Zebu, ações educacionais e o desenvolvimento da Turma do Zebuzinho com o Gerente do Museu do Zebu, Thiago Riccioppo, Editor da Bela Vista Cultural, Fábio Ávila e Sócio-di...
64: GESTÃO DA PROPRIEDADE NA OVINOCULTURA
 Publicado em 2020-06-30 06:08:10 por #Embrapa [206 hits]
Publicado em 2020-06-30 06:08:10 por #Embrapa [206 hits]
Participação da Embrapa na Agrotins 2020, primeiro grande evento agropecuário nacional totalmente digital. A empresa participou por meio de várias de suas Unidades de Pesquisa....
 Publicado em 2020-06-30 06:08:10 por #Embrapa [206 hits]
Publicado em 2020-06-30 06:08:10 por #Embrapa [206 hits]Participação da Embrapa na Agrotins 2020, primeiro grande evento agropecuário nacional totalmente digital. A empresa participou por meio de várias de suas Unidades de Pesquisa....
65: LIVE ABMRA SOBRE MARKETING RURAL
 Publicado em 2020-06-30 06:07:51 por #CanalRural [202 hits]
Publicado em 2020-06-30 06:07:51 por #CanalRural [202 hits]
Live realizada em 29/06/20 pela Associação Brasileira de Marketing Rural e Agronegócio (ABMRA)....
 Publicado em 2020-06-30 06:07:51 por #CanalRural [202 hits]
Publicado em 2020-06-30 06:07:51 por #CanalRural [202 hits]Live realizada em 29/06/20 pela Associação Brasileira de Marketing Rural e Agronegócio (ABMRA)....
66: PROGRAMA AGRICULTURA BR - 29/06/20
 Publicado em 2020-06-30 06:00:15 por #CanalDoBoi [201 hits]
Publicado em 2020-06-30 06:00:15 por #CanalDoBoi [201 hits]
Envie sua dúvida ou sugestão de pauta no WhatsApp: (67) 99264-7810...
 Publicado em 2020-06-30 06:00:15 por #CanalDoBoi [201 hits]
Publicado em 2020-06-30 06:00:15 por #CanalDoBoi [201 hits]Envie sua dúvida ou sugestão de pauta no WhatsApp: (67) 99264-7810...
67: O QUE FAZER PARA AUMENTAR O CONSUMO DE CARNE SUÍNA NO BRASIL?
 Publicado em 2020-06-30 05:59:45 por #CanalRural [359 hits]
Publicado em 2020-06-30 05:59:45 por #CanalRural [359 hits]
"O Brasil já investe em carnes suínas produzidas em ambientes naturais. Esse deve ser o grande incentivo para o setor nos próximos anos", garantiu Alexandre Furtado Rosa, presidente da Associação...
 Publicado em 2020-06-30 05:59:45 por #CanalRural [359 hits]
Publicado em 2020-06-30 05:59:45 por #CanalRural [359 hits]"O Brasil já investe em carnes suínas produzidas em ambientes naturais. Esse deve ser o grande incentivo para o setor nos próximos anos", garantiu Alexandre Furtado Rosa, presidente da Associação...
68: CONTROLE DE BICHO-MINEIRO DO CAFÉ, NAS CONDIÇÕES CLIMÁTICAS DE CERRADO
 Publicado em 2020-06-30 05:51:41 por #RevistaCafeicultura [258 hits]
Publicado em 2020-06-30 05:51:41 por #RevistaCafeicultura [258 hits]
Instruções para o controle de bicho-mineiro do café, cafeeiro, nas condições climáticas de Cerrado. Resultados atuais de 11 experimentos montados na Estacão Experimental Santinato Cafés 2, Pat...
 Publicado em 2020-06-30 05:51:41 por #RevistaCafeicultura [258 hits]
Publicado em 2020-06-30 05:51:41 por #RevistaCafeicultura [258 hits]Instruções para o controle de bicho-mineiro do café, cafeeiro, nas condições climáticas de Cerrado. Resultados atuais de 11 experimentos montados na Estacão Experimental Santinato Cafés 2, Pat...
69: PROGRAMA DE PÓS-GRADUAÇÃO DO INSTITUTO DE FÍSICA DA UNICAMP SELECIONA ESTUDANTES
Publicado em 30/06/2020 às 05:50: por #Fapesp [201 hits]
Inscrições podem ser feitas até 15 de julho para os cursos de mestrado e doutorado. São oferecidas 12 linhas de pesquisa (foto: Unicamp) Agência FAPESP – O Programa de Pós-Graduação em ...
Publicado em 30/06/2020 às 05:50: por #Fapesp [201 hits]
Inscrições podem ser feitas até 15 de julho para os cursos de mestrado e doutorado. São oferecidas 12 linhas de pesquisa (foto: Unicamp) Agência FAPESP – O Programa de Pós-Graduação em ...